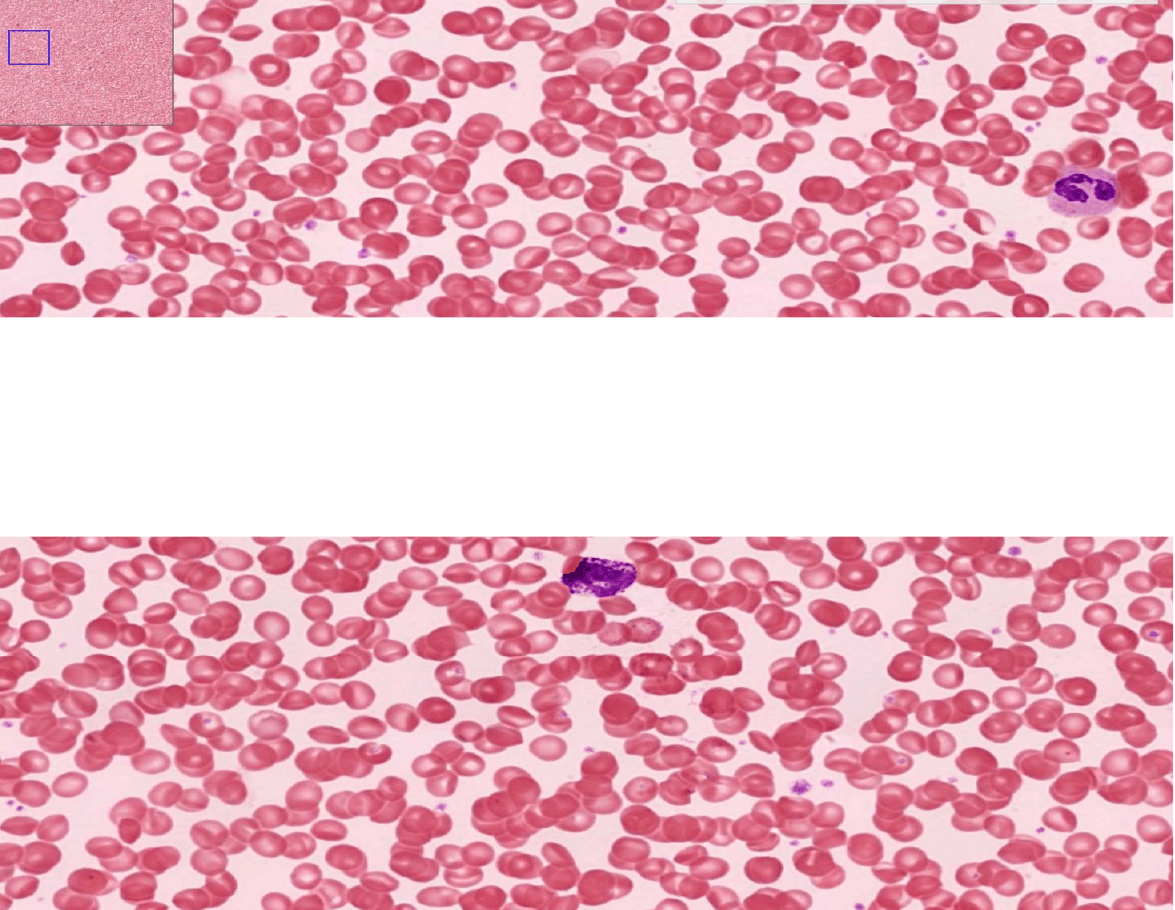

Tejido sanguíneo

Tejido sanguíneo
Tejido conjuntivo liquido que circula
através del sistema cardiovascular
Componentes
Células sanguíneas:
glóbulos rojos o hematíes
Glóbulos blancos o leucocitos
Trombocitos (plaquetas)
Eritrocitos
Neutrófilos
Eosinófilos
Basófilos
Linfocitos
Monocitos
Granulosos o
polinorfonucleares
Neutrófilo
Basófilo
Eosinófilo
Agranulocitos
Linfocito
Monocito
Glóbulos rojos(hematíes)
Glóbulos blancos(leucocitos)
Células sanguinas
-
-

Matriz extracelular: plasma sanguíneo
Globulinas
Fibrinogeno
Inmunoglobulinas (Ig) y las globulinas
No inmunes
Ig: son los secretados por los
plasmocitos
Globulinas no inmunes: son secretadas por el hígado
Mantienen la presión osmótica
Hb-haptoglobina
Fe-transferencia
Cu-ceruloplasmia
Es la proteína más grande
Sintetizada por el hígado
Coagulación= fibrinógeno Fibrina Coágulo
Agua
Proteínas
Gases
Sustrato de
nitrógeno
Nutrientes
Hormonas
Diferencia entre suero y plasma
El plasma tiene fibrinogeno y al suero no se le meten
anticoagulantes,
no tiene fibrinógeno
÷
i
¿
nó
o
O
6
SE
^
9-
Ee
E-
30
JEET
@
•


Eritrocitos
No tienen núcleo.
Viven aproximadamente 120 días.
Forma discoide y bicóncavo.
Son degradados en el sistema retículo
endotelial: principalmente por el
Bazo,médula ósea e hígado
Tiene capacidad para modificar su
forma (deformación)
Concentración 4,5 a 5,5 millones x mm3
Función:
Contienen Hemoglobina
Fijan oxigeno en los pulmones para
entregarlos en los tejidos donde fijan el
dióxido de carbono para llevarlo a los
pulmones
Vista microscópica
Hemoglobina
Tres tipos
-Hb A1
-Hb A2
-Hb F
Posee 4 sitios de unión para el oxígeno,
donde un grupo hemo se une a un pelipéptido
Grupo hemo posee un
radical de fe + 2
_
usó
o
←
É
o
O
G
-0
§
Es
B
o
E
J
o
s
É
^

Sistemas de grupos sanguíneos ABO
§
÷
:
i
J
i
:
:
←

Plaquetas o trombocitos
Son restos de otras células de mayor tamaño
Son pequeños fracheños citoplasmático (3um)
Son biconvexas
No tienen núcleo
Vida medí es de 10 días
Provienen de los megacariocitos de 19 médula ósea
Cantidad normal: 150 mil a 400 mil
Función
Hemastomasia: retención de hemorragias
(coagulación)
Mantenimiento de endorelio: pdgf
Contribuyen a la formación de plasmina.
Alfa: mas abundante) contienen
fibrinogeno, factores de
coagulación, factor de
crecimiento.
Delta: ADP,ATP, serotonina e
histamina
Gamma: enzimas hidrolíticas
É
O
£
%
±
§
UÉ

Leucocitos (glóbulos blancos )
Glóbulos Blancos
Neutrófilos
Linfocitos
Monocitos
Basófilos
Leucopenia: menos de 4.000
Normal (4.000 - 10.000)
(Eucocitosis:+de 10.000
¥
E-
•
E
E
E

Neutrofilos (10-12 micras)
Núcleo 3-5 lóbulos
Hexerocromatina en la periferia
citoplasma poco teñido
Son los
leucocitos más
abundantes y los granulocitos
más comunes
Núcleo muy lobulado
Es un tipo de glóbulo blanco
Función
Son células inmunológicas que actúan a
nivel titular: defensa contra las
infecciones principalmente bacterianas
Tienen propiedades fagocitosis activa en
sitios de inflamación
:
÷
Es
>
O
§
.
÷
:

Granulocitos neutrófilos
Contienen tres tipos de gránulos:
Gránulos azurófilos: mas grandes, son los lisosomas del, neutrofilo,
contienen milloperoxidasa,hidrolasas y defensinas
Gránulos específicos: muy pequeños, contienen: enzimas ( colagenasa Tipo IV
fostolipasa) activadores del complementos agentes bacteriostático y
bactericidas (lisozima)
Granulosas terciarios: pueden ser de dos tipos: Fagosoma que contienen
fosfatasa o los que contienen metaloproteinas
NO
@
De

Granulocitos eosinófilos (12-15
micras)
Núcleo o bilobulado
Granulo azurofilos
-Lisosomas
-Hidrolasas ácidas
Función: activo frente a infecciones parasitarias
Se elevan en reacciones alérgicas

Granulocitos basófilos (12 - 15 micras )
Son los menos abundantes de todos los
leucocitos. Sus granulos se tiñen con colorantes
básicos.
Núcleo lobulado, queda oculto tras los gránulos
Origen: médula ósea
Constituye menos del 1% de la población
Función: inducir el proceso inflamatorio
Pueden ser redondas en suspensión
Función:
Íntimamente relacionada con mastocitos
Fijan igE» hipersensibilidad Y anafilaxia

Agranulocitos
Monocitos (12 - 18 micras)
Precursoras de las células del sistema
fagocítico mononuclear
(macrofago)
Células grandes
Núcleo arriñonado
Citoplasma basofilo
Función:
transformarse en macrófago
( cuando
llega a los tejidos) para ser una célula
presentadora de ag. Fagocitar bacterias
y partículas inanimadas (no muere
después de fagocitar)

Linfocitos
Principalmente las células del sistema linfático o inmune
Células pequeñas
Contienen un núcleo grande y escaso citoplasma muy basofilo
Contienen gránulos azurófilos
Función: vigilancia inmunológica
Tipos de linfocitos:
Representa el 20% al 30% de la población total
de leucocitos
Suele aumentar cuando el organismo es
infectado por ciertos MO
De acuerdo a su función: linfocitos T (80%)
linfocitos B (15%) y nulos (5%)
¡
ÉÉ
O
T
-
P
,
E
E
O
÷
:
a.
•
ha

Hematopoyesis
Eritropoyesis → proeritroblastos → eritrocitos
Leucopoyesis
Mieloblasto → neutrofilos, eosinofilos y basofilos.
Linfoblasto → linfocitos.
Monoblasto → monolitos
Plaquetopoyesis » megacariocitos → plaquetas
⑨
③
①
Este documento contiene más páginas...
Descargar Completo
Bloc de notas sin título (3) (1).pdf
 Estamos procesando este archivo...
Estamos procesando este archivo...
 Lamentablemente la previsualización de este archivo no está disponible. De todas maneras puedes descargarlo y ver si te es útil.
Lamentablemente la previsualización de este archivo no está disponible. De todas maneras puedes descargarlo y ver si te es útil.
Descargar
 Estamos procesando este archivo...
Estamos procesando este archivo...
 Lamentablemente la previsualización de este archivo no está disponible. De todas maneras puedes descargarlo y ver si te es útil.
Lamentablemente la previsualización de este archivo no está disponible. De todas maneras puedes descargarlo y ver si te es útil.